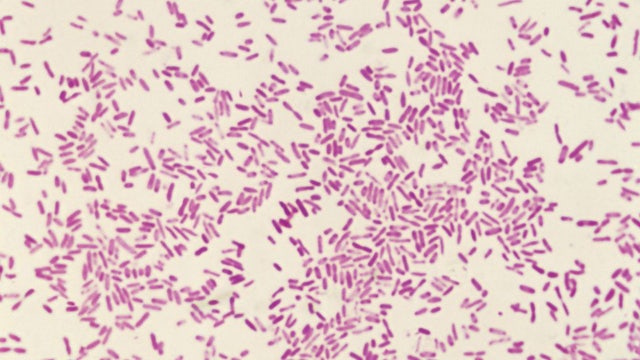
Oregon dysentery outbreak: 7 new cases reported in February so far

2 people shot in Portland identified as possible Tren de Aragua members, DHS claims
DHS said the two people in the car were also undocumented immigrants.
DHS said the two people in the car were also undocumented immigrants.
US border agents involved in Portland shooting, 2 people injured, officials say
The assistant secretary of the department of homeland security shared on X that the passengers of the vehicle were believed to be part of the Tren de Aragua, also known as a "megabanda," a category the local press in Venezuela use to refer to large organized criminal groups.
The assistant secretary of the department of homeland security shared on X that the passengers of the vehicle were believed to be part of the Tren de Aragua, also known as a "megabanda," a category the local press in Venezuela use to refer to large organized criminal groups.
Portland protester accused of threatening officers and their families at ICE facility
John Paul Cupp, 45, is accused of making violent threats at an Immigration and Customs Enforcement (ICE) building in South Portland.
John Paul Cupp, 45, is accused of making violent threats at an Immigration and Customs Enforcement (ICE) building in South Portland.
Liquor store employee robbed while suffering cardiac arrest, later dies
Authorities are investigating a robbery at a Portland liquor store where an employee suffered a medical emergency and later died.
Authorities are investigating a robbery at a Portland liquor store where an employee suffered a medical emergency and later died.
Former Alaska Airlines pilot who tried to cut engines mid-flight gets no prison time
“Pilots are not perfect. They are human," U.S. District Court Judge Amy Baggio said. “They are people and all people need help sometimes."
“Pilots are not perfect. They are human," U.S. District Court Judge Amy Baggio said. “They are people and all people need help sometimes."
Trump says Portland is next city where he's sending troops
President Donald Trump said he’s sending troops to Portland, Oregon, expanding his controversial deployments to more American cities and “authorizing Full Force, if necessary."
President Donald Trump said he’s sending troops to Portland, Oregon, expanding his controversial deployments to more American cities and “authorizing Full Force, if necessary."
Man drowns after falling into deep ocean pit along Oregon coastline
According to locals, Thor's Well likely began as a sea cave, which collapsed into a giant hole that is estimated to be around 20 feet deep.
According to locals, Thor's Well likely began as a sea cave, which collapsed into a giant hole that is estimated to be around 20 feet deep.
Deputies find man living in crawl space at Oregon complex
Oregon authorities say a 40-year-old man was arrested after deputies found him living inside a crawl space at a condominium complex.
Oregon authorities say a 40-year-old man was arrested after deputies found him living inside a crawl space at a condominium complex.
Video shows teens’ adventure turn frightening near popular tourist destination
Helicopter crew hoisted stranded teenagers and a firefighter to safety just yards from a dangerous Oregon coastline.
Helicopter crew hoisted stranded teenagers and a firefighter to safety just yards from a dangerous Oregon coastline.
Baby seal stabbed on Oregon coast; search for suspect underway
The baby seal survived the attack which occurred in March.
The baby seal survived the attack which occurred in March.
Dashcam footage shows shocking 'road rage' hit-and-run on motorcyclist
Police in Oregon shared shocking dashcam video that shows a driver swerving into a motorcyclist, causing him to lose control and skid across the highway.
Police in Oregon shared shocking dashcam video that shows a driver swerving into a motorcyclist, causing him to lose control and skid across the highway.
'Odd-looking' deep sea fish washes up on beach, surprising locals: 'Would not expect to run across'
Longnose lancetfish "look like they swam out of prehistoric time," NOAA says.
Longnose lancetfish "look like they swam out of prehistoric time," NOAA says.
Access to America's deepest lake is closing to tourists: What to know
If you’ve always wanted to swim or ride a boat in America’s deepest lake, this summer is your last chance to do it for a few years.
If you’ve always wanted to swim or ride a boat in America’s deepest lake, this summer is your last chance to do it for a few years.
Missing Oregon toddler found dead in river died from drowning, authorities say
Authorities have confirmed that 2-year-old Dane Paulsen, who was found dead in Oregon’s Siletz River, died from drowning.
Authorities have confirmed that 2-year-old Dane Paulsen, who was found dead in Oregon’s Siletz River, died from drowning.
Oregon dysentery outbreak: 7 new cases reported in February so far
Shigella bacteria can lead to shigellosis, a disease that can cause dysentery.
Shigella bacteria can lead to shigellosis, a disease that can cause dysentery.
Dysentery outbreak in Oregon leaves at least 40 sickened: What to know
The illness is mostly spread from person to person, and no specific “origin” has been pinpointed for the outbreak.
The illness is mostly spread from person to person, and no specific “origin” has been pinpointed for the outbreak.
Search continues for missing Oregon toddler last seen in front yard
Authorities are searching for Dane Paulsen, a toddler who went missing Saturday from his front yard in Oregon.
Authorities are searching for Dane Paulsen, a toddler who went missing Saturday from his front yard in Oregon.
Insurance CEO's home riddled with bullets; gunman remains on the run
SAIF CEO Chip Terhune said he received a threatening email from the purported gunman in a message to company employees.
SAIF CEO Chip Terhune said he received a threatening email from the purported gunman in a message to company employees.
Oregon man arrested, charged in stabbing death of Cherry Hill veterinarian
Camden County officials have announced the arrest of an Oregon man in connection with the December 2024 fatal stabbing of a Cherry Hill veterinarian.
Camden County officials have announced the arrest of an Oregon man in connection with the December 2024 fatal stabbing of a Cherry Hill veterinarian.
Whiteout conditions cause massive pileup on I-84 in Oregon
I-84 closed near Multnomah Falls, Oregon, after whiteout winter weather conditions led to a massive pileup on Thursday.
I-84 closed near Multnomah Falls, Oregon, after whiteout winter weather conditions led to a massive pileup on Thursday.